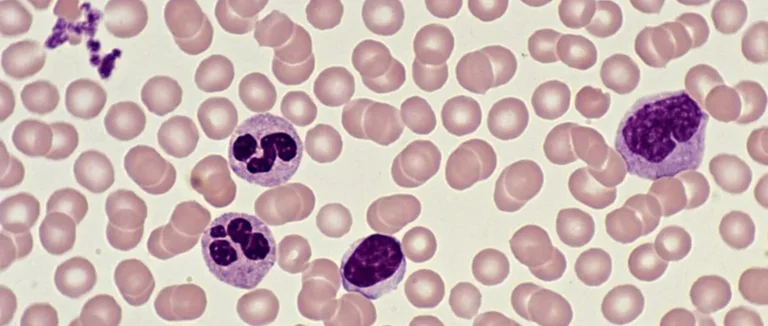

Qu'est-ce que la Thérapie Adjuvante ? Un Guide Complet de Définition
-
La Thérapie Adjuvante : Définition et Importance
-
Le Rôle de la Thérapie Adjuvante dans le Traitement du Cancer
-
Quand la Thérapie Adjuvante Est-elle Recommandée ?
-
Types de Thérapie Adjuvante
-
Efficacité de la "Adjuvant Therapy" : Données Scientifiques
-
La Thérapie Adjuvante pour Différents Types de Cancer
-
Effets Secondaires et Gestion des Complications
-
Durée et Planification du Traitement Adjuvant
-
Différence Entre Thérapie Adjuvante et Néoadjuvante
-
Innovations et Avenir de la Thérapie Adjuvante
-
Conclusion
-
FAQ

Chaque année, des millions de patients atteints de cancer doivent décider si poursuivre une thérapie supplémentaire. Cette décision est cruciale après le traitement principal. Ils doivent savoir si cette thérapie peut éliminer les cellules cancéreuses microscopiques que l'imagerie ne détecte pas.
La thérapie adjuvante est une méthode scientifiquement prouvée. Elle aide à réduire les récidives de cancer et à améliorer la survie à long terme.
À l'hôpital Liv, nous mettons l'accent sur les soins centrés sur le patient. Nous utilisons des protocoles médicaux fondés sur des preuves. Nous savons que cette thérapie est essentielle pour les patients atteints de cancer.
Points clés à retenir
● La thérapie adjuvante est un traitement supplémentaire donné après le traitement principal pour réduire le risque de récidive de cancer.
● Cette approche est scientifiquement prouvée pour améliorer la survie à long terme.
● Les cellules cancéreuses microscopiques sont la cible de cette thérapie.
● L'hôpital Liv propose des soins centrés sur le patient et des protocoles médicaux fondés sur des preuves.
● La thérapie adjuvante est une partie clé des soins complets pour les patients atteints de cancer.
La Thérapie Adjuvante : Définition et Importance
Dans l'oncologie, la thérapie adjuvante est très importante. Elle est un traitement qui aide après la thérapie principale. Son but est de diminuer le risque de retour du cancer.
Origine et signification du terme "adjuvant"
Le mot "adjuvant" vient du latin "adjuvare", qui signifie "aider". Dans le traitement du cancer, c'est un élément clé. La thérapie adjuvante vise à éliminer les cellules cancéreuses microscopiques restantes.
Place dans le parcours de traitement du cancer
La thérapie adjuvante est souvent associée à la chirurgie ou à la chimiothérapie. Son objectif est de diminuer le risque de retour du cancer. Cela augmente les chances de guérison à long terme pour les patients.
Voici un tableau illustrant les différents types de thérapie adjuvante et leur utilisation :
| Type de Thérapie Adjuvante | Description | Utilisation |
| Chimiothérapie adjuvante | Administration de médicaments anticancéreux après la chirurgie | Récidive du cancer du sein, du côlon, etc. |
| Radiothérapie adjuvante | Traitement par rayonnement après la chirurgie | Récidive locale du cancer du sein, de la tête et du cou, etc. |
| Hormonothérapie adjuvante | Traitement hormonal pour les cancers sensibles aux hormones | Cancer du sein hormonosensible |
En conclusion, la thérapie adjuvante est essentielle dans le traitement du cancer. Elle diminue le risque de retour du cancer et améliore les résultats pour les patients.
Le Rôle de la Thérapie Adjuvante dans le Traitement du Cancer

La thérapie adjuvante aide à combattre les cellules cancéreuses restantes. Elle est cruciale après la chirurgie ou d'autres traitements pour éliminer les cellules cancéreuses microscopiques. Cela améliore les chances de guérison des patients.
Nous allons voir comment la thérapie adjuvante cible les cellules cancéreuses microscopiques. Et comment elle réduit le risque de récidive du cancer.
Ciblage des cellules cancéreuses microscopiques
La thérapie adjuvante vise les cellules cancéreuses microscopiques. Ces cellules ne sont pas visibles avec les examens standards. La chimiothérapie adjuvante, par exemple, utilise des médicaments pour tuer ces cellules cancéreuses microscopiques.
La thérapie adjuvante est un traitement complémentaire. Elle vise à réduire le risque de récidive du cancer. Les traitements adjuvants comprennent la chimiothérapie, la radiothérapie, l'hormonothérapie et la thérapie ciblée. Chacun est conçu pour éliminer les cellules cancéreuses résiduelles.
Réduction du risque de récidive
Le but principal de la thérapie adjuvante est de diminuer le risque de récidive. En éliminant les cellules cancéreuses microscopiques, elle prévient la réapparition du cancer. Les études montrent que cette thérapie améliore les taux de survie sans maladie pour plusieurs cancers, comme le cancer du sein, du côlon et du poumon.
Nous utilisons la thérapie adjuvante pour compléter les traitements primaires. Cela assure que les cellules cancéreuses restantes soient éliminées. Cela améliore les résultats du traitement et offre aux patients de meilleures chances de guérison.
Quand la Thérapie Adjuvante Est-elle Recommandée ?
La thérapie adjuvante est très importante dans le traitement du cancer. Mais quand est-elle conseillée ? Cette question préoccupe beaucoup les médecins et les patients.
La décision de faire appel à la thérapie adjuvante dépend de plusieurs critères. Nous allons voir ces critères et comment on évalue les avantages et les risques.
Facteurs déterminant la nécessité d'un traitement adjuvant
Plusieurs éléments influencent la décision de faire une thérapie adjuvante. Voici quelques-uns d'entre eux :
● Le type de cancer : Certains cancers sont plus susceptibles de bénéficier d'une thérapie adjuvante en raison de leur nature agressive ou de leur stade avancé.
● Le stade du cancer : Les cancers diagnostiqués à un stade avancé nécessitent souvent une thérapie adjuvante pour réduire le risque de récidive.
● L'état de santé général du patient : La condition physique et les antécédents médicaux du patient influencent la décision de recourir à une thérapie adjuvante.
Des études montrent que la thérapie adjuvante diminue de beaucoup la mortalité due au cancer. Elle réduit les taux de mortalité de 35 à 72 %.
Évaluation des risques et bénéfices
Évaluer les risques et les avantages de la thérapie adjuvante est crucial. Les médecins doivent comparer les avantages potentiels à la réduction du risque de récidive et à l'amélioration de la survie. Ils doivent aussi considérer les risques et les effets secondaires possibles du traitement.
Cette évaluation est très personnalisée. Elle prend en compte le type de cancer, la santé globale du patient et ses préférences personnelles.
En conclusion, décider de faire une thérapie adjuvante est une décision importante. Elle résulte d'une discussion approfondie entre le patient et son équipe soignante. Le but est de trouver la meilleure stratégie de traitement.
Types de Thérapie Adjuvante
La thérapie adjuvante aide à diminuer le risque de retour du cancer. Elle est donnée après la chirurgie ou d'autres traitements. Son but est d'éliminer les cellules cancéreuses restantes.
Chimiothérapie adjuvante
La chimiothérapie adjuvante utilise des médicaments pour combattre les cellules cancéreuses. C'est très utile pour les cancers à haut risque de retour.
Une étude a montré que cette thérapie améliore la survie sans maladie. Cela est vrai pour certains types de cancer.
Radiothérapie adjuvante
La radiothérapie adjuvante utilise des radiations pour détruire les cellules cancéreuses. Elle est souvent utilisée après une opération pour les cancers à risque de retour local.
Un expert a dit : "La radiothérapie adjuvante est très utile contre le cancer. Elle permet de cibler les cellules tumorales."
Hormonothérapie adjuvante
L'hormonothérapie adjuvante est pour les cancers sensibles aux hormones. Cela inclut certains cancers du sein et de la prostate. Son objectif est de réduire les hormones ou d'empêcher leur action sur les cellules cancéreuses.
Thérapie ciblée adjuvante
La thérapie ciblée adjuvante utilise des médicaments ciblés. Ils visent les cellules cancéreuses selon leurs caractéristiques génétiques ou moléculaires. Cela protège les cellules saines.
| Type de Thérapie | Description | Application |
| Chimiothérapie adjuvante | Utilise des médicaments pour tuer les cellules cancéreuses restantes | Cancers avec risque élevé de récidive |
| Radiothérapie adjuvante | Utilise des radiations pour détruire les cellules cancéreuses locales | Cancers avec risque de récidive locale |
| Hormonothérapie adjuvante | Réduit les niveaux d'hormones ou empêche leur action sur les cellules cancéreuses | Cancers sensibles aux hormones |
| Thérapie ciblée adjuvante | Cible spécifiquement les cellules cancéreuses en fonction de leurs caractéristiques | Cancers avec marqueurs génétiques ou moléculaires spécifiques |
Efficacité de la "Adjuvant Therapy" : Données Scientifiques
La thérapie adjuvante a changé le traitement du cancer. Elle améliore beaucoup les résultats pour les patients. Voyons les preuves scientifiques qui prouvent son efficacité.
Réduction de la mortalité
Beaucoup d'études montrent que la thérapie adjuvante diminue la mortalité. Les traitements adjuvants visent les cellules cancéreuses restantes. Cela réduit le risque de retour du cancer et augmente les chances de guérison.
Par exemple, pour le cancer du sein, la chimiothérapie adjuvante diminue le risque de décès de façon importante. De même, pour le cancer du côlon, les traitements adjuvants ont prouvé leur efficacité dans la réduction de la mortalité.
Amélioration de la survie sans maladie
La thérapie adjuvante améliore aussi la survie sans maladie. Cela signifie que les patients ont moins de risques de voir leur cancer revenir.
● La radiothérapie adjuvante est efficace contre le cancer du sein et d'autres types.
● L'hormonothérapie adjuvante montre des résultats prometteurs contre les cancers hormono-dépendants.
● La thérapie ciblée adjuvante améliore les résultats pour certains types de cancer.
Résultats des essais cliniques majeurs
Plusieurs essais cliniques majeurs ont étudié l'efficacité de la thérapie adjuvante. Ces études ont donné des preuves solides sur les avantages de cette approche.
Par exemple, un essai sur le cancer du sein a montré que la chimiothérapie adjuvante réduit le risque de récidive de 30%. De même, des études sur le cancer du côlon ont montré que les traitements adjuvants améliorent la survie sans maladie.
En conclusion, les données scientifiques confirment l'importance de la thérapie adjuvante dans le traitement du cancer. Les résultats des essais cliniques majeurs et les améliorations dans la survie sans maladie et la réduction de la mortalité montrent son rôle crucial dans le traitement du cancer.
La Thérapie Adjuvante pour Différents Types de Cancer
La thérapie adjuvante est un traitement important pour combattre le cancer. Elle aide à éliminer les cellules cancéreuses restantes après la chirurgie. Cela diminue le risque de retour du cancer.
Cancer du Sein
Pour le cancer du sein, cette thérapie réduit le risque de retour du cancer. Les traitements peuvent être la chimiothérapie, l'hormonothérapie ou la radiothérapie. Ils dépendent de la tumeur et de l'état de santé de la patiente.
Cancer du Côlon
Le cancer du côlon est souvent traité avec de la chimiothérapie adjuvante. Cela aide à éliminer les cellules cancéreuses microscopiques restantes. Cela diminue le risque de retour du cancer et améliore la survie.
Cancer du Poumon
Le traitement du cancer du poumon inclut souvent la chimiothérapie et/ou la radiothérapie. Ces traitements visent à détruire les cellules cancéreuses restantes. Ils aident à prévenir le retour du cancer et améliorent les chances de guérison.
Cancer du Pancréas
Le cancer du pancréas nécessite souvent une thérapie adjuvante en raison du risque élevé de retour après la chirurgie. La chimiothérapie adjuvante est souvent recommandée. Elle améliore la survie et réduit le risque de retour du cancer.
En conclusion, la thérapie adjuvante est cruciale dans le traitement du cancer. Elle offre de grands avantages en réduisant la récidive et en améliorant la survie.
Effets Secondaires et Gestion des Complications
La gestion des effets secondaires est essentielle dans la thérapie adjuvante. Cela améliore la qualité de vie des patients. La thérapie adjuvante est cruciale contre le cancer mais peut causer des effets secondaires.
Effets secondaires courants
Les effets secondaires dépendent du traitement. La chimiothérapie peut causer des nausées, des vomissements et de la fatigue. La radiothérapie peut provoquer des réactions cutanées et de la fatigue. L'hormonothérapie peut causer des bouffées de chaleur et des changements d'humeur.
Chaque patient réagit différemment. La communication avec l'équipe soignante est cruciale pour gérer ces effets.
Stratégies de gestion
Pour gérer les effets secondaires, plusieurs stratégies existent. Les médicaments anti-nauséeux peuvent aider contre les nausées. Les crèmes et les lotions peuvent soulager les réactions cutanées.
● Adapter son alimentation pour minimiser les nausées
● Utiliser des produits de soins de peau pour les réactions cutanées
● Pratiquer des exercices légers pour maintenir la force et réduire la fatigue
Il est important de suivre les conseils de l'équipe soignante pour gérer les effets secondaires.
Quand consulter un médecin
Il est crucial de savoir quand consulter un médecin. Si les effets secondaires deviennent sévères, contactez l'équipe soignante. Des signes comme des difficultés respiratoires ou des saignements inhabituels nécessitent une attention immédiate.
En comprenant les effets secondaires et en utilisant des stratégies de gestion, les patients peuvent mieux vivre leur traitement. Cela améliore leur qualité de vie.
Durée et Planification du Traitement Adjuvant
La durée et la planification du traitement adjuvant sont essentielles pour les patients atteints de cancer. Chaque patient est unique, donc le traitement adjuvant est personnalisé.
Le traitement adjuvant est crucial dans le plan de soins contre le cancer. Il vise à éliminer les cellules cancéreuses restantes après la chirurgie.
Calendrier typique des traitements
Le calendrier des traitements adjuvants varie selon le type de cancer et l'état de santé du patient. Par exemple, la chimiothérapie pour le cancer du sein est donnée toutes les trois semaines pendant plusieurs mois.
Voici un exemple de calendrier pour différents traitements adjuvants :
● Chimiothérapie adjuvante : toutes les trois semaines pendant 3 à 6 mois
● Radiothérapie adjuvante : quotidiennement pendant plusieurs semaines
● Hormonothérapie adjuvante : quotidiennement pendant 5 à 10 ans
Facteurs influençant la durée
Plusieurs facteurs déterminent la durée du traitement adjuvant. Le type et le stade du cancer, ainsi que la réponse du patient, sont importants. Les effets secondaires et la tolérance au traitement sont aussi cruciaux.
Nous évaluons ces facteurs pour déterminer la durée optimale du traitement. Cela aide à maximiser l'efficacité tout en réduisant les effets secondaires.
En conclusion, la planification et la durée du traitement adjuvant nécessitent une approche personnalisée. Nous visons à offrir des soins de qualité adaptés à chaque patient.
Différence Entre Thérapie Adjuvante et Néoadjuvante
Les thérapies adjuvante et néoadjuvante sont deux méthodes pour combattre le cancer. Chacune a ses propres buts et avantages. Comprendre ces différences aide les patients et les médecins à faire le bon choix.
Définition de la thérapie néoadjuvante
La thérapie néoadjuvante est donnée avant la chirurgie ou la radiothérapie principale. Son objectif est de diminuer la taille de la tumeur. Cela permet aux médecins de voir si le traitement marche bien avant de continuer.
Les avantages majeurs de la thérapie néoadjuvante sont :
● Elle réduit la taille de la tumeur, ce qui aide à la chirurgie.
● Elle permet d'évaluer si le traitement est efficace.
● Elle peut aider à garder les organes sains.
Quand choisir l'une plutôt que l'autre
Le choix entre la thérapie adjuvante et la néoadjuvante dépend de plusieurs éléments. Ces éléments incluent le type de cancer, la taille de la tumeur, et l'état de santé du patient. Voici un tableau comparatif des deux :
| Caractéristiques | Thérapie Adjuvante | Thérapie Néoadjuvante |
| Chronologie | Après la chirurgie principale | Avant la chirurgie principale |
| Objectif | Éliminer les cellules cancéreuses restantes | Réduire la taille de la tumeur |
| Avantages | Réduction du risque de récidive | Facilitation de la chirurgie, évaluation de la réponse au traitement |
En conclusion, la thérapie adjuvante et la néoadjuvante sont deux stratégies importantes dans le combat contre le cancer. Le choix entre elles dépend de la situation de chaque patient.
Innovations et Avenir de la Thérapie Adjuvante
L'avenir de la thérapie adjuvante est plein d'espoir. Les avancées en médecine personnalisée et les nouvelles méthodes de traitement promettent de changer la donne. Les chercheurs travaillent dur pour améliorer l'efficacité de la thérapie adjuvante. Ils cherchent aussi à offrir de nouvelles options aux patients atteints de cancer.
Nouvelles Approches en Développement
Des thérapies ciblées sont en développement. Elles visent directement les cellules cancéreuses tout en protégeant les tissus sains. Les essais cliniques en cours évaluent leur efficacité et leur potentiel.
L'immunothérapie est un exemple intéressant. Elle aide le système immunitaire à combattre les cellules cancéreuses. Cette méthode a déjà montré des résultats prometteurs pour différents types de cancer.
| Nouvelle Approche | Description | Avantages Potentiels |
| Thérapie Ciblée | S'attaque spécifiquement aux cellules cancéreuses | Moins de dommages aux tissus sains, réduction des effets secondaires |
| Immunothérapie | Stimule le système immunitaire pour attaquer les cellules cancéreuses | Réponses durables, amélioration de la survie |
Médecine Personnalisée et Thérapie Adjuvante
La médecine personnalisée est de plus en plus importante dans la thérapie adjuvante. En analysant les tumeurs, les médecins peuvent adapter les traitements. Cela maximise leur efficacité.
Cette approche personnalisée améliore les résultats pour les patients. Elle réduit aussi les effets secondaires des traitements traditionnels.
En conclusion, l'avenir de la thérapie adjuvante est plein d'espoir. Les innovations continuent d'offrir de nouvelles perspectives pour les patients atteints de cancer. Les avancées en médecine personnalisée et les nouvelles méthodes de traitement vont révolutionner le domaine.
Conclusion
Dans ce guide complet, nous avons exploré la thérapie adjuvante. Elle joue un rôle crucial dans le traitement du cancer. Nous avons vu les différents types de thérapies adjuvantes disponibles.
La thérapie adjuvante est essentielle dans la lutte contre le cancer. Elle aide à réduire le risque de récidive. Cela améliore aussi les taux de survie des patients.
Nous avons examiné l'utilisation de la thérapie adjuvante pour différents cancers. Cela inclut le cancer du sein, du côlon, du poumon et du pancréas. Les données scientifiques montrent son efficacité pour réduire la mortalité et améliorer la survie sans maladie.
En résumé, la thérapie adjuvante est un élément vital du traitement du cancer. Elle offre des bénéfices importants pour les patients. Nous espérons que ce guide vous a donné une bonne compréhension de la thérapie adjuvante et de son importance dans la lutte contre le cancer.
FAQ
Qu'est-ce que la thérapie adjuvante ?
La thérapie adjuvante est un traitement qui aide après le premier traitement. Elle vise à éliminer les cellules cancéreuses restantes. Cela diminue le risque de retour du cancer.
Quelle est la différence entre la thérapie adjuvante et la thérapie néoadjuvante ?
La thérapie adjuvante vient après le premier traitement. La thérapie néoadjuvante vient avant pour réduire la taille de la tumeur.
Quels sont les types de thérapie adjuvante ?
Il existe plusieurs types de thérapie adjuvante. On a la chimiothérapie, la radiothérapie, l'hormonothérapie et la thérapie ciblée.
Quand la thérapie adjuvante est-elle recommandée ?
Elle est conseillée quand le risque de retour du cancer est haut. Cela est aussi vrai quand des cellules cancéreuses restent après le premier traitement.
Quels sont les avantages de la thérapie adjuvante ?
Elle diminue le risque de retour du cancer. Elle améliore aussi la chance de vivre sans maladie plus longtemps. Et elle augmente les chances de guérir.
Quels sont les effets secondaires de la thérapie adjuvante ?
Les effets secondaires dépendent du traitement. Ils peuvent inclure la fatigue, les nausées, les vomissements et la perte de cheveux.
Comment gérer les effets secondaires de la thérapie adjuvante ?
Il existe des médicaments et des changements de style de vie pour gérer ces effets. Les soins de soutien sont aussi importants.
Quelle est la durée typique de la thérapie adjuvante ?
La durée varie selon le traitement et la réponse du patient. Elle peut durer de quelques mois à plusieurs années.
La thérapie adjuvante est-elle efficace pour tous les types de cancer ?
Elle est efficace pour certains cancers comme le cancer du sein, du côlon et du poumon. Mais son efficacité dépend du type et du stade du cancer.
* Le contenu de notre site web est uniquement destiné à des fins d'information. Veuillez consulter votre médecin pour obtenir un diagnostic et un traitement. Le contenu de la page ne contient pas d'informations sur les services de santé thérapeutiques de l'hôpital Liv. .